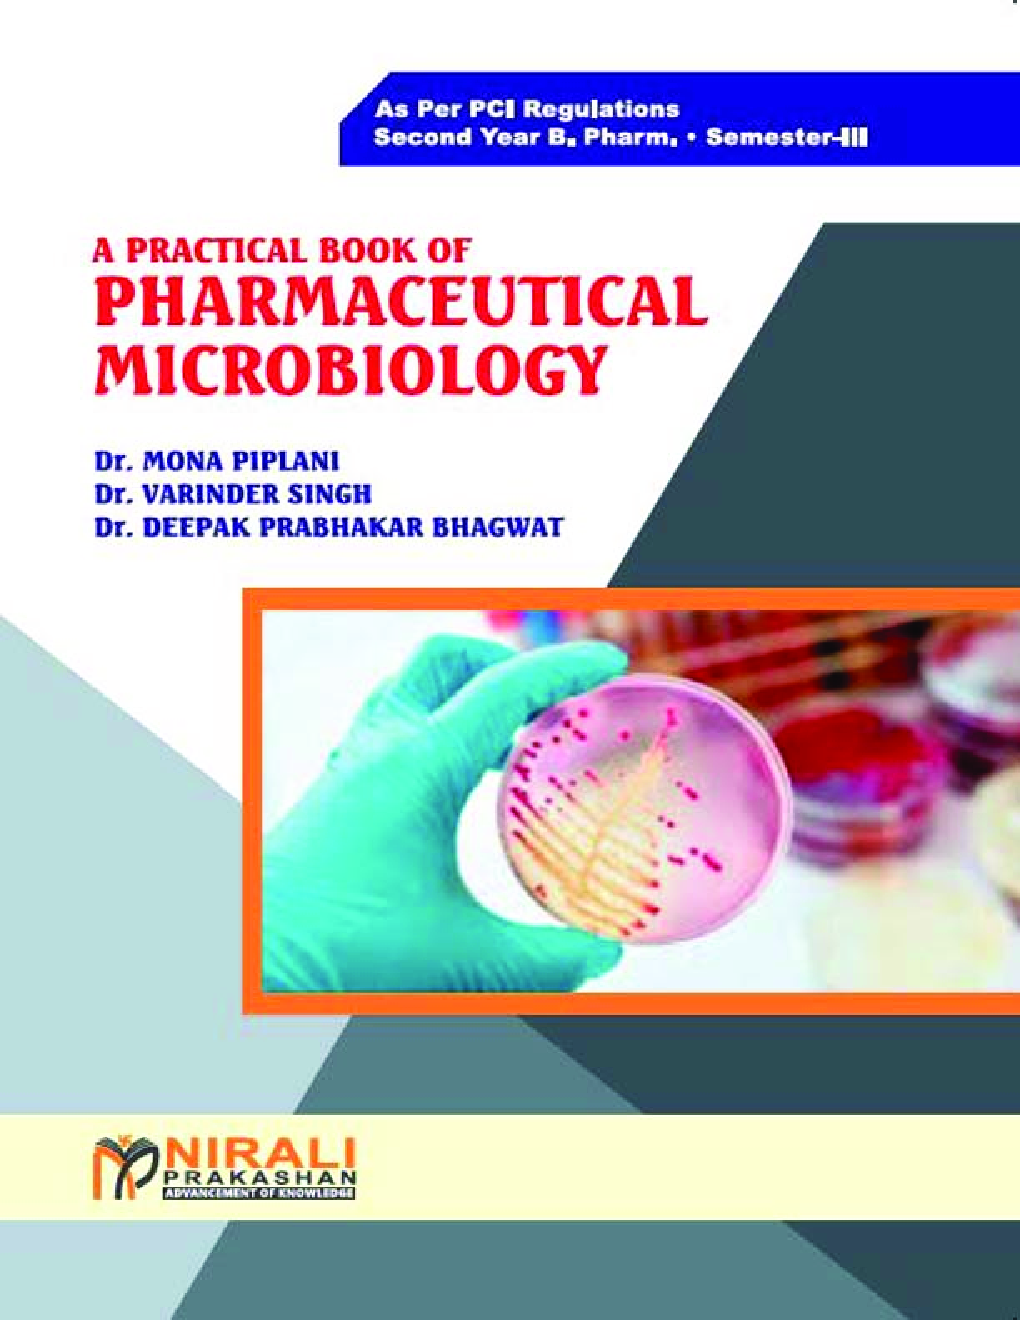
Practical Pharmaceutical Microbiology - Page 1

Practical Pharmaceutical Microbiology by Dr. Mona Piplani, Dr. Varinder Singh, Dr. Deepak Prabhakar Bhagwat
Book Summary:
Pharmacy Council of India, New Delhi, the apex regulatory body controlling Pharmacy Profession in the country has come out with the regulations viz. Bachelor of Pharmacy (B. Pharm) course regulations 2014 for B. Pharm degree program based on CBSC pattern. Pharmaceutical Microbiology has been included in the course of study for Semester III. This course has been designed to provide basic knowledge required to understand the science of Microbiology with special reference to Pharmacy.
Audience of the Book :
This book Useful for Pharmacy Student.
Table of Content:
1. Laboratory Safety
2. Sterilization
3. Media
4. Staining
5. Pure Culture
6. Antibiotic Assay
7. Motility Determination
8. Sterility Testing
9. Bacteriological Analysis
10. Biochemical Tests